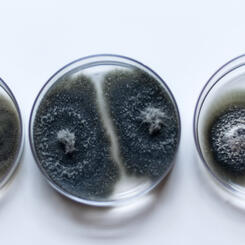
Mold spores in Petri dishes
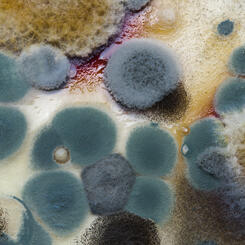
Close-up mold spores on paper
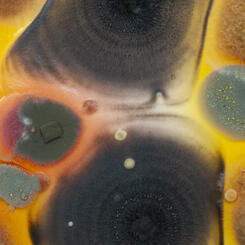
Close up mold spores on paper
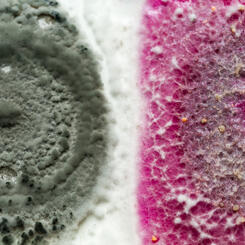
Close up mold spores on paper

Work samples
-
 Faces Installation View
Faces Installation View2025
Mold spores taken from participants, Polaroid image transfer, boards, epoxy resin
6x6" eachThe Contamination Series utilizes mold spores collected from my surroundings to make the invisible microbiome visible, while documenting, preserving, and creating a historical record of the microbial life that exists around me. I create large-scale installations formed by microorganisms on different-sized panels. These panels are later assembled to construct an abstract landscape.
-
 Faces (Details)
Faces (Details)2025
Mold spores taken from participants, Polaroid image transfer, boards, epoxy resin
6x6""Balci’s Faces replaces blank panels with Polaroid portraits of staff from the Baltimore Museum of Art and her friends and family. Balci collected invisible microorganisms from each person’s body and applied the samples to their corresponding photograph, growing mold spores directly on the image. She reimagines portraiture beyond the visible, illustrating the complex and often-overlooked ecosystems within and around us. The project underscores the interconnectedness of human life and the microbial world, reminding us of our shared existence with the organisms that shape and sustain our environment."
Curated by Katie Cooke, BMA Manager of Curatorial Affairs, and Antoinette Roberts, BMA Assistant Curator of Contemporary Art.
At the Baltimore Museum of Art, April 2025 -
My process
About Selin

Selin Balci is an interdisciplinary artist and researcher who merges art and science through innovative use of biological materials, scientific tools, and traditional art supplies. Her work is categorized as bio-art, a contemporary artistic approach that incorporates living organisms into creative expression. With a background in both science and art, Selin adeptly explores the dynamic relationship between the natural world and human intervention within this emerging field. Selin holds a… more
Biological materials in my work
I am an interdisciplinary artist blending traditional art methods with scientific processes and biological materials, especially mold spores. My work uncovers the unseen micro-world by turning invisible microorganisms into tangible forms, giving viewers a direct experience of the living systems around us. I develop visual and interactive landscapes based on the growth and behavior of these hidden organisms. By collecting mold spores from air, soil, plants, trees, and human environments, I isolate and culture each source's unique microbiome. In synthetic yet liveable environments, these spores grow and interact, showing patterns of coexistence, tension, and transformation across my work’s surfaces. As the mold germinates, it expresses itself through color, texture, and shape, leaving physical traces that serve as both record and expression. This process allows microorganisms to move from microscopic to visible, turning my panels into living, changing canvases. The mold spores actively participate as living agents of abstraction, shaping organic compositions that constantly evolve through growth and decay.
-
 Mold spores in Petri dishes
Mold spores in Petri dishesMy work uses mold spores collected from my environment to make the invisible microbiome visible, while also documenting and preserving a record of microbial life around me. I create large-scale installations with microorganisms cultivated on panels of various sizes. These panels are then assembled into abstract landscapes, unveiling the unseen world through organic growth and interactions. I gather these organisms from soil, plants, and trees, isolating them to study their natural behaviors. In a controlled, yet habitable environment, I observe how these living beings interact, struggle, and coexist across each panel's surface. During germination, the mold spores leave traces—colors, textures, and shapes—directly on the panel, which functions as a living canvas. Once finished, these microorganisms shift from the micro to the macro scale, becoming visible to the eye. In this process, mold spores serve as both subject and medium—transforming into a dynamic, expressive form of abstraction. Through my work, I reveal and build invisible landscapes, making the microscopic world tangible and perceptible.
-
 Mold spores in Petri dishes
Mold spores in Petri dishesMy background in microbiology has a profound influence on my artistic practice. My previous research focused on pathogen biology, investigating how these organisms exist, interact, and impact their environment. This scientific inquiry—centered on understanding microbial life dynamics—now informs my artwork's conceptual and practical aspects.
I approach my art with the same precision and methodology I used in the laboratory. Through my work, I explore simple living organisms, cultivating them in controlled environments to observe their interactions. I meticulously document how these microorganisms engage with one another within Petri dishes, capturing the intricate behaviors, patterns, and aesthetics that emerge through their interactions. These processes reveal scientific insights and unexpected beauty as the microbes imprint vibrant colors, textures, and organic forms.
By merging scientific methods with artistic expression, I create a unique window into the hidden world of microbes, bridging the gap between the laboratory and the gallery, the microscopic and the tangible.
-
 Close-up mold spores on paper
Close-up mold spores on paperDue to their microscopic size, microorganisms often go unnoticed, representing an unseen world hidden from our everyday perception. To bring this world into view, I use growth media—a nutrient-rich base made from potatoes—to create a living platform for the microbes I cultivate. Essentially, I construct a small, self-contained 'world' for these organisms, providing the conditions they need to thrive. Once introduced to this environment, the microorganisms are left to grow, interact, and exist according to their own natural rules, creating unpredictable patterns and forms that reveal the complexity of life on a microscopic scale.
-
 Close-up mold spores on paper
Close-up mold spores on paperWhen cultured in growth media, microorganisms reveal themselves through vibrant colors. These colors emerge from pigments within their cellular structures and from the compounds they secrete, which can alter the color of the growth medium itself. Through this process, the once-invisible microorganisms become visible, transforming the microscopic world into a tangible, observable landscape of color and form.
-
 Close up mold spores on paper
Close up mold spores on paper -
 Close up mold spores on paper
Close up mold spores on paper -
 Close up mold spores on paper
Close up mold spores on paper -
 Close up mold spores on paper
Close up mold spores on paper -
My process
Contamination Series, 2019-2025
Contamination Series
Ongoing work since 2011
Contamination Series uses the mold spores collected from my surroundings to make the invisible microbiome visible while documenting, preserving, and creating a historical record of microbial life existing around me. I create large-scale installations formed by microorganisms on different-sized panels. These panels later assemble to construct an abstract landscape.
I isolate these organisms from soil, plants, and trees. I incubate them in a synthetic but habitable environment where I witness living organisms' interactions, struggles, and conflicts across the picture surface. When germinating, mold spores physically inscribe their colors and form on the surface of a panel, which is the living platform. Once the work is completed, microorganisms shift from the micro-world to the macro-world and have a physical appearance. They serve as a painting agent where I make the invisible landscape, visible.
-
 Contamination '66'
Contamination '66'2025
Mold Spores on boards covered with epoxy resin
8x10'
At Staten Island Museum, NY -
 Contamination '66'
Contamination '66'Contamination '66'
2025
Mold Spores on boards covered with epoxy resin
8x10'
At Staten Island Museum, NY -
 Contamination '66'
Contamination '66'2025
Mold Spores on boards covered with epoxy resin
8x10'
At Staten Island Museum, NY -
 Contamination '66'
Contamination '66'2025
Mold spores on boards covered with resin
10x10'
At the Baltimore Museum of Art
Created with mold spores taken from Wyman Park, Baltimore, MD -
 Contamination (39° 19.718′ N, 76° 37.326′ W)
Contamination (39° 19.718′ N, 76° 37.326′ W)2025
Mold spores on boards covered with resin
10x10'
At the Baltimore Museum of Art
Created with mold spores taken from Wyman Park, Baltimore, MD -
 Contamination (39° 19.718′ N, 76° 37.326′ W)
Contamination (39° 19.718′ N, 76° 37.326′ W)Contamination (39° 19.718′ N, 76° 37.326′ W)
2025
Mold spores on boards covered with resin
10x10'
At the Baltimore Museum of Art
Created with mold spores taken from Wyman Park, Baltimore, MD -
 Colony '50'Colony '50', 2021, Mold spores on panels covered with resin, 8x9ft At Hamiltonian Gallery, Washington DC I use live microscopic mold that leaves physical inscriptions by direct contact on the surface of a paper or board, which creates a living platform. In Contamination Series, the surface of each panel is laced with graceful, brilliant mold until the entire surface is covered and patterned with circular borders
Colony '50'Colony '50', 2021, Mold spores on panels covered with resin, 8x9ft At Hamiltonian Gallery, Washington DC I use live microscopic mold that leaves physical inscriptions by direct contact on the surface of a paper or board, which creates a living platform. In Contamination Series, the surface of each panel is laced with graceful, brilliant mold until the entire surface is covered and patterned with circular borders -
 Colony '50'Colony '50', 2021, Mold spores on panels covered with resin, 8x9ft At Hamiltonian Gallery, Washington DC
Colony '50'Colony '50', 2021, Mold spores on panels covered with resin, 8x9ft At Hamiltonian Gallery, Washington DC -
My Process
Faces
Faces
2025
Mold spores taken from participants, Polaroid image transfer, boards, epoxy resin
6x6" each
"Balci’s Faces replaces blank panels with Polaroid portraits of staff from the Baltimore Museum of Art and her friends and family. Balci collected invisible microorganisms from each person’s body and applied the samples to their corresponding photograph, growing mold spores directly on the image. She reimagines portraiture beyond the visible, illustrating the complex and often-overlooked ecosystems within and around us. The project underscores the interconnectedness of human life and the microbial world, reminding us of our shared existence with the organisms that shape and sustain our environment."
Curated by Katie Cooke, BMA Manager of Curatorial Affairs, and Antoinette Roberts, BMA Assistant Curator of Contemporary Art.
At the Baltimore Museum of Art, April 2025
-
 30 Faces installation view
30 Faces installation viewMold spores taken from participants, Polaroid image transfer, boards, and epoxy resin
6x6" each -
 Faces Installation View
Faces Installation View2025
Mold spores taken from participants, Polaroid image transfer, boards, epoxy resin
6x6" each -
 Faces Installation View
Faces Installation View2025
Mold spores taken from participants, Polaroid image transfer, boards, epoxy resin
6x6" each -
 Faces (Details)
Faces (Details)2025
Mold spores taken from participants, Polaroid image transfer, boards, epoxy resin
6x6""Balci’s Faces replaces blank panels with Polaroid portraits of staff from the Baltimore Museum of Art and her friends and family. Balci collected invisible microorganisms from each person’s body and applied the samples to their corresponding photograph, growing mold spores directly on the image. She reimagines portraiture beyond the visible, illustrating the complex and often-overlooked ecosystems within and around us. The project underscores the interconnectedness of human life and the microbial world, reminding us of our shared existence with the organisms that shape and sustain our environment."
Curated by Katie Cooke, BMA Manager of Curatorial Affairs, and Antoinette Roberts, BMA Assistant Curator of Contemporary Art.
At the Baltimore Museum of Art, April 2025 -
 Faces (Details)
Faces (Details)2025
Mold spores taken from participants, Polaroid image transfer, boards, epoxy resin
6x6" -
 Faces (Details)
Faces (Details)2025
Mold spores taken from participants, Polaroid image transfer, boards, epoxy resin
6x6" -
 Faces (Details)
Faces (Details)2025
Mold spores taken from participants, Polaroid image transfer, boards, epoxy resin
6x6" -
 Faces (Details)
Faces (Details)2025
Mold spores taken from participants, Polaroid image transfer, boards, epoxy resin
6x6" -
Process
Echoes of Nature
Echoes of Nature
2023
Documentation of Mold spores
1:51 min
My recent focus has been on human impacts on nature. These impacts can be profound, ranging from environmental changes that adversely influence biodiversity to climate change. Echoes of Nature vividly portrays the harmful impact of environmental issues on the planet. I started by taking a Polaroid photo of a landscape, which served as the foundation for the project. To bring attention to the issue, I intentionally added mold spores from the exact location to the environment to slowly destroy the unique Polaroid landscape. A time-lapse video was created to show a week's destruction in just two minutes. The video also features an alarm sound, slowed down to remind us of the urgent need for action to protect our planet. Echoes of Nature is a powerful call to action, urging us to take responsibility for the environment and work towards a sustainable future.
-
Echoes of The Nature
Echoes of Nature
2023
Documentation of Mold spores
1:51 minEchoes of Nature explores the profound human impact on the environment, addressing pressing issues such as biodiversity loss and climate change. The project began with a Polaroid photograph of a landscape, serving as both a visual and conceptual foundation. To emphasize the fragility of these environments, I introduced mold spores collected from the same location onto the Polaroid, allowing the spores to gradually consume and transform the image. A time-lapse video captures this week-long process of decay, condensing it into two minutes, accompanied by the sound of an alarm—slowed down to underscore the urgency of our environmental crisis. Echoes of Nature serves as both a reflection and a call to action, reminding us of the delicate balance we are disrupting and urging collective responsibility to protect and restore our planet for a sustainable future.
-
Mass MoCA LandscapeMold spores collected from Mass MoCA residency, 32 sec, 2022
Growth
Growth, 2023
Mold spores on wood, 15'
In this project, I collect microorganisms from various sources, including air, soil, plants, trees, and humans, and cultivate them within a synthetic environment to support their growth. The microorganisms develop on prepared wooden boards, where the germinating mold spores leave behind vibrant colors, textures, and organic shapes, forming abstract compositions. Over time, these microorganisms become visible, transitioning from the microscopic realm to the visual world. This process allows me to observe the dynamic interactions, struggles, and conflicts unfolding between these life forms across the surface of the panels.
The installation features multiple wooden boards showcasing visible microbial growth, representing the intricate microbiome surrounding us. Through this work, I aim to highlight microorganisms' essential yet often unnoticed role in our lives. These tiny life forms are fundamental to many processes, including nutrient cycling, decomposition, fermentation, soil fertility, food and medicine production, and immune system regulation. Without microorganisms, life on Earth would be vastly different and unsustainable.
The primary goal of this project is to raise awareness of the microbial world that coexists with us by giving these organisms a tangible, visible presence. By visualizing these invisible communities, we can foster a deeper appreciation for their significance and better understand the interconnectedness between humans and microorganisms. This knowledge is essential for environmental stewardship, as recognizing the critical role of microorganisms can inspire actions to protect and sustain our ecosystems.
Contamination Series, 2013-2018
-
 Annapolis (Highland Beach)Microscopic mold on panels, 40x100”, 2018 at School 33 Gallery, Baltimore, Maryland. In this work, I used microscopic mold that is collected from Highland Beach, Annapolis to create an unseen landscape of the scene. Emerging from a diverse array of mold, this work interprets the landscape with invisible inhabitants.
Annapolis (Highland Beach)Microscopic mold on panels, 40x100”, 2018 at School 33 Gallery, Baltimore, Maryland. In this work, I used microscopic mold that is collected from Highland Beach, Annapolis to create an unseen landscape of the scene. Emerging from a diverse array of mold, this work interprets the landscape with invisible inhabitants. -
 Annapolis (Highland Beach)Microscopic mold on panels, 40x100”, 2018
Annapolis (Highland Beach)Microscopic mold on panels, 40x100”, 2018 -
 Contamination 28Contamination'28', mold on panels, 60x60", 2014 at Trawick Prize Exhibition, Gallery B, Bethesda, Maryland. DESCRIPTION: I use live microscopic mold that leaves physical inscriptions by direct contact on the surface of a paper or board, which creates a living platform. In Contamination Series, the surface of each panel is laced with graceful, brilliant mold until the entire surface is covered and patterned with circular borders. Then, I assembled these forms and shapes that mold produced, to create various visual references that can relate to both natural and human impacted landscapes. The forms have similarities to human-induced activities on the landscape. They create territories, boundaries, and borderlines and end up with conflicts on the picture surface. "Balci gives living microbes a place to grow and organize themselves on specially prepared plates. The microorganisms, which normally are invisible to the naked eye, are made visible in these conditions. They create maps of “territories” as they battle for the food sources, and their behavior is disturbingly parallel to many scenarios of human conflict. The artist organizes and assembles the landscapes or maps that result from these natural migrations into abstract compositions that are limited in tonal variation but elegant in form." by Claudia Rousseau, Gazette.net, September 18, 2013.
Contamination 28Contamination'28', mold on panels, 60x60", 2014 at Trawick Prize Exhibition, Gallery B, Bethesda, Maryland. DESCRIPTION: I use live microscopic mold that leaves physical inscriptions by direct contact on the surface of a paper or board, which creates a living platform. In Contamination Series, the surface of each panel is laced with graceful, brilliant mold until the entire surface is covered and patterned with circular borders. Then, I assembled these forms and shapes that mold produced, to create various visual references that can relate to both natural and human impacted landscapes. The forms have similarities to human-induced activities on the landscape. They create territories, boundaries, and borderlines and end up with conflicts on the picture surface. "Balci gives living microbes a place to grow and organize themselves on specially prepared plates. The microorganisms, which normally are invisible to the naked eye, are made visible in these conditions. They create maps of “territories” as they battle for the food sources, and their behavior is disturbingly parallel to many scenarios of human conflict. The artist organizes and assembles the landscapes or maps that result from these natural migrations into abstract compositions that are limited in tonal variation but elegant in form." by Claudia Rousseau, Gazette.net, September 18, 2013. -
 Contamination 28 (detail)Contamination'28', mold on panels, 60x60", 2014 at Trawick Prize Exhibition, Gallery B, Bethesda, Maryland.
Contamination 28 (detail)Contamination'28', mold on panels, 60x60", 2014 at Trawick Prize Exhibition, Gallery B, Bethesda, Maryland. -
 Contamination 28 (detail)Contamination'28', mold on panels, 60x60", 2014 at Trawick Prize Exhibition, Gallery B, Bethesda, Maryland.
Contamination 28 (detail)Contamination'28', mold on panels, 60x60", 2014 at Trawick Prize Exhibition, Gallery B, Bethesda, Maryland. -
 Contamination 32Contamination 32, mold on panels, 70x70", 2013 The University of Maryland, College Park Stamp Student Union, Contemporary Art Permanent Collection, College Park, MD.
Contamination 32Contamination 32, mold on panels, 70x70", 2013 The University of Maryland, College Park Stamp Student Union, Contemporary Art Permanent Collection, College Park, MD. -
 Contamination 32Contamination 32, mold on panels, 70x70", 2013 The University of Maryland, College Park Stamp Student Union, Contemporary Art Permanent Collection, College Park, MD.
Contamination 32Contamination 32, mold on panels, 70x70", 2013 The University of Maryland, College Park Stamp Student Union, Contemporary Art Permanent Collection, College Park, MD. -
 Contamination 32Contamination 32, mold on panels, 70x70", 2013 The University of Maryland, College Park Stamp Student Union, Contemporary Art Permanent Collection, College Park, MD.
Contamination 32Contamination 32, mold on panels, 70x70", 2013 The University of Maryland, College Park Stamp Student Union, Contemporary Art Permanent Collection, College Park, MD. -
 Contamination IIContamination II (detail), mold on panels, 60x110", 2012 at ConnerSmith Gallery, Washignton, DC
Contamination IIContamination II (detail), mold on panels, 60x110", 2012 at ConnerSmith Gallery, Washignton, DC -
 Contamination II (detail)Contamination II (detail), mold on panels, 60x110", 2012 at ConnerSmith Gallery, Washignton, DC
Contamination II (detail)Contamination II (detail), mold on panels, 60x110", 2012 at ConnerSmith Gallery, Washignton, DC
Contamination Series, 2011-2012
by CHRISTINA CAUTERUCCI SEPTEMBER 19TH, 2014
-
 Contamination IContamination I, Mold on panels, 70x220", 2012 at University of Maryland Art Gallery, College Park, Maryland
Contamination IContamination I, Mold on panels, 70x220", 2012 at University of Maryland Art Gallery, College Park, Maryland -
 Contamination IContamination I, Mold on panels, 70x220", 2012 at University of Maryland Art Gallery, College Park, Maryland
Contamination IContamination I, Mold on panels, 70x220", 2012 at University of Maryland Art Gallery, College Park, Maryland -
 Contamination IContamination I, Mold on panels, 70x220", 2012 at University of Maryland Art Gallery, College Park, Maryland
Contamination IContamination I, Mold on panels, 70x220", 2012 at University of Maryland Art Gallery, College Park, Maryland -
 Contamination IContamination I, Mold on panels, 70x220", 2012 at University of Maryland Art Gallery, College Park, Maryland
Contamination IContamination I, Mold on panels, 70x220", 2012 at University of Maryland Art Gallery, College Park, Maryland -
 BoundBound, Mold on panels, each 11x14", 2011 at The Pearl Conard Art Gallery, The Ohio State University, Mansfield, Ohio
BoundBound, Mold on panels, each 11x14", 2011 at The Pearl Conard Art Gallery, The Ohio State University, Mansfield, Ohio -
 BoundBound, Mold on panels, each 11x14", 2011 at The Pearl Conard Art Gallery, The Ohio State University, Mansfield, Ohio
BoundBound, Mold on panels, each 11x14", 2011 at The Pearl Conard Art Gallery, The Ohio State University, Mansfield, Ohio -
 StructuresStructures, Mold on panels, 10x10" each, 2012 at Hamiltonian Gallery, Washington DC.
StructuresStructures, Mold on panels, 10x10" each, 2012 at Hamiltonian Gallery, Washington DC. -
 StructuresStructures, Mold on panels, 10x10" each, 2012 at Hamiltonian Gallery, Washington DC.
StructuresStructures, Mold on panels, 10x10" each, 2012 at Hamiltonian Gallery, Washington DC.
Bordered World
Bordered World creates a competition for resources, territorial wars, and struggle for power and control among living organisms. In this project, I reference the fundamental, underlying social dilemmas and principles of our existence in an effort to understand and highlight social issues. My concepts are explored using living entities such as fungus and mold to recreate observable interactions and conflicts across the picture surface, where the outcomes reveal boundaries, edges and distinctive forms. In Bordered World, all vital resources are restricted. This limited environment makes microbes compete for resources, dominate a particular area or become invasive and endanger others. When they share the same living platform, a conflict for resources arise and eventually this results with a borderline. The behaviors of the microorganisms resemble human actions and motives. Visually representing the world map, these microbes act as metaphors for war and the human predicament.
"In Selin Balci’s bio-art installation Bordered World, 2,500 Petri dishes compose a three-dimensional kaleidoscopic world map representing the universal struggle for survival and dominance. Within each hand “painted” Petri dish, live molds and fungi are in an observable battle for limited resources. Distinctive borders slowly form and new colonies develop during this microscopic feud."
Smack Mellon Curator
-
 Bordered WorldEvolving mold in 2500 Petri dishes at Smack Mellon, Brooklyn, NY, 2014-15
Bordered WorldEvolving mold in 2500 Petri dishes at Smack Mellon, Brooklyn, NY, 2014-15 -
 Bordered WorldEvolving mold in 2500 Petri dishes at Smack Mellon, Brooklyn, NY, 2014-15
Bordered WorldEvolving mold in 2500 Petri dishes at Smack Mellon, Brooklyn, NY, 2014-15 -
 Bordered WorldEvolving mold in 2500 Petri dishes at Smack Mellon, Brooklyn, NY, 2014-15
Bordered WorldEvolving mold in 2500 Petri dishes at Smack Mellon, Brooklyn, NY, 2014-15 -
 Bordered WorldEvolving mold in 2500 Petri dishes at Smack Mellon, Brooklyn, NY, 2014-15
Bordered WorldEvolving mold in 2500 Petri dishes at Smack Mellon, Brooklyn, NY, 2014-15 -
 Bordered WorldEvolving mold in 2500 Petri dishes at Smack Mellon, Brooklyn, NY, 2014-15
Bordered WorldEvolving mold in 2500 Petri dishes at Smack Mellon, Brooklyn, NY, 2014-15 -
Installation of Bordered World at Smack Mellon galleryEvolving mold in 2500 Petri dishes at Smack Mellon, Brooklyn, NY, 2014-15
The World
"If the artistic process is more interesting than the outcome, as some modernists hold, then the greatest artist is nature itself. Its systems are endless and inexorable, even if the results aren’t always impressive to the naked eye. Take, for example, the fungal experiments of Selin Balci, one of five former Hamiltonian Artists fellows who return to the gallery in “Empirical Evidence.” The Turkey-born Marylander is exhibiting such seemingly inert items as petri dishes that contain slowly evolving mold spores. Far more dramatic is a more artist-directed piece, a five-minute fast-motion video in which molds spread across a world map. It demonstrates the power and scope of the tiniest living things."
Mark Jenkins, October 1, 2021, The Washington Post
"The map-based works present this phenomenon in stark terms, played out as geopolitical headlines ripped from the paper. The World depicts worlds run amok by war, disease or possibly famine. Faint pencil outlines suggest physical boundaries that the organisms push to the brink. Teaming and frothing, they have no “place” to go, and so they turn on one another in a game of brinkmanship, drawing boundaries with battlegrounds to gain the upper hand. The pieces are both eerie and transfixing, haunting yet mesmerizing, and their underlying message could be ignored offhand, if not because we see similar battles taking place today in regions as remote as Syria and as near as Dallas." Eric Hope for East City Art, 2014.
-
 The WorldThe World (4th version), 2020, Mold spores on panel covered with epoxy resin, 24x40" I used mold to specifically refer to human behavior, culture and society. The world's political map was re-created on a board with growth media (food), then different microorganisms were placed to represent each country. The work demonstrates human actions, form of power, political pressures, immigration, racialism and the dominance of superior countries.
The WorldThe World (4th version), 2020, Mold spores on panel covered with epoxy resin, 24x40" I used mold to specifically refer to human behavior, culture and society. The world's political map was re-created on a board with growth media (food), then different microorganisms were placed to represent each country. The work demonstrates human actions, form of power, political pressures, immigration, racialism and the dominance of superior countries. -
 The World (5th version)The World (5th version), 2020, Mold spores on panel covered with epoxy resin, 16x20"
The World (5th version)The World (5th version), 2020, Mold spores on panel covered with epoxy resin, 16x20" -
The WorldThe World, video, originally 4:33min, 2010 I used mold to specifically refer to human behavior, culture, and society. The world's political map was re-created on a board with growth media (food), then different microorganisms were placed to represent each country. The work demonstrates human actions, forms of power, political pressures, immigration, racialism, and the dominance of superior countries.
-
 The World (1st version)Mold spores on panel, 2012, 24x40"
The World (1st version)Mold spores on panel, 2012, 24x40"